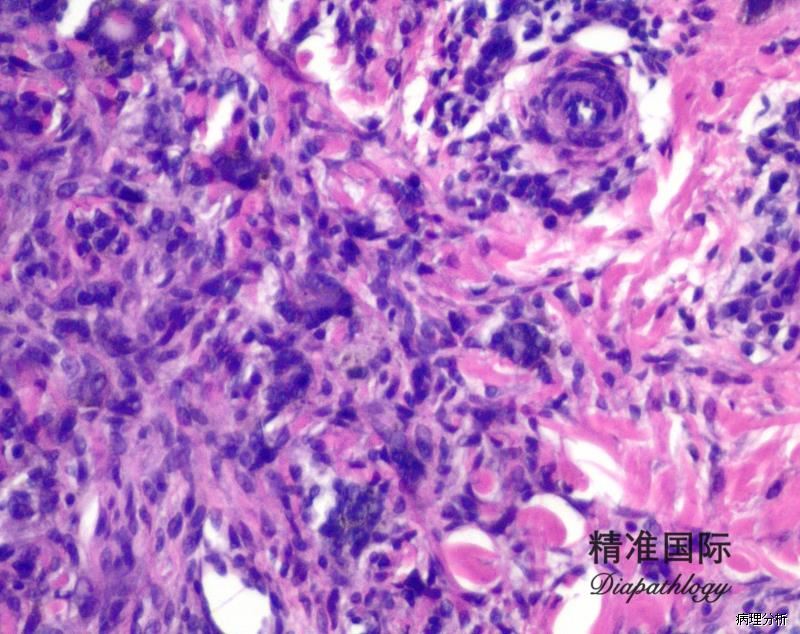

皮肤纤维瘤
Dermatofibroma
同义词(或曾用名): 皮肤纤维组织细胞瘤
发病部位: 上臂和肩部
诊断要点:
好发于青年人上臂和肩部,呈斑块样病变;
肿瘤由形态一致的梭形肌纤维母细胞和纤维母细胞所组成,瘤细胞长轴与表皮平行
细胞无明显异型性,无或很少核分裂像;
可有散在的淋巴、浆细胞,无泡沫样组织细胞或巨细胞。

免疫组织化学染色:
α-SMA 和 MSA 常阳性,β-catenin (核)阳性,而 desmin 阴性; 偶见 CD117. 角蛋白及 calretinin 阳性(可能会成为陷阱); 多数可表达激素受体(ER 或 PR)。
鉴别诊断:
1. 隆突性皮肤纤维肉瘤
2. 神经纤维瘤: S100 阳性可与皮肤纤维瘤鉴别。
预后:
良性。
治疗:
手术局部切除
